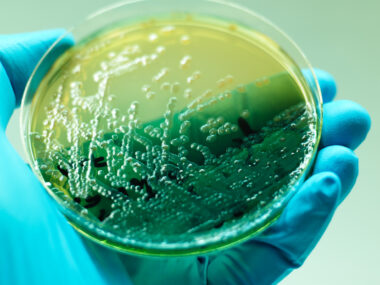
Recida Therapeutics

Why colon cancer screenings are essential for adults with CF
Colonoscopy prep is a pain, but protecting my health is worth the effort
Written by |

When people think of cystic fibrosis (CF), colon cancer usually isn’t the first thing that comes to mind. But for those of us living beyond what used to be the limits of this disease, it’s become an important and very real concern.
Thanks to advances in treatments, many in the CF community are living longer, fuller lives. With that gift of longevity come new challenges, including a significantly increased risk for colorectal cancer. Research shows that people with CF are five to 10 times more likely to develop colorectal cancer than the general population, with transplant recipients facing even higher risks.
That’s why the Cystic Fibrosis Foundation recommends that adults with CF begin colonoscopy screenings at age 40, or 30 if they’ve had an organ transplant. This is 10-15 years earlier than recommended for healthy adults.
The dreaded colonoscopy prep
By the time this column publishes, I’ll be at the hospital undergoing my routine colonoscopy screening. I’ve spent many days doing the CF bowel prep — a process that’s more intense than most people realize. I’m hoping my extensive efforts will pay off with a smooth procedure and precise results.
For someone without CF, bowel prep is already unpleasant. For me, it’s a logistical and physical marathon. CF causes my body to produce thick, sticky mucus — not just in my lungs, but also throughout my digestive system. Constipation and malabsorption are common in our community, and can make a thorough “clean-out” challenging to achieve. But it is essential for accurate colonoscopy results.
My daily routine already includes taking Miralax (polyethylene glycol 3350) and Colace (docusate sodium) to maintain normal bowel function. This regimen isn’t optional for me; it’s survival. I was born with meconium ileus and had bowel surgery to correct the blockage on my second day of life. Since then, I’ve battled painful distal intestinal obstruction syndrome and multiple dangerous bowel obstructions.
Colonoscopy prep means supercharging that already intensive daily routine. It requires more potent laxatives, dietary restrictions, and, most critically, aggressive hydration. Dehydration poses a real threat when you’re flushing your system so thoroughly. I rely on home-infusion hydration during prep to prevent dangerous drops in blood pressure and debilitating fatigue, especially because I live alone.
This process is daunting, invasive, exhausting, and, frankly, frustrating. But I do it because prevention matters more than comfort. Unlike many CF complications that emerge without warning, colon cancer is something I can be proactive about. Early detection saves lives.
If you have CF and are approaching 40 — or 30 with a transplant history — please discuss scheduling a colonoscopy with your care team. It’s challenging, but worth it. Screening isn’t just about finding cancer; it’s about preventing it. Doctors can remove polyps before they become malignant. That opportunity is invaluable.
I’m focusing on getting through today by trusting my medical team, my body, and my faith. I’ve completed the prep, maintained my hydration, and shown up. I have done all I can do.
Here’s to hoping my efforts yield clean results and more years of living well despite CF.
Note: Cystic Fibrosis News Today is strictly a news and information website about the disease. It does not provide medical advice, diagnosis, or treatment. This content is not intended to be a substitute for professional medical advice, diagnosis, or treatment. Always seek the advice of your physician or other qualified health provider with any questions you may have regarding a medical condition. Never disregard professional medical advice or delay in seeking it because of something you have read on this website. The opinions expressed in this column are not those of Cystic Fibrosis News Today or its parent company, Bionews, and are intended to spark discussion about issues pertaining to cystic fibrosis.

Leave a comment
Fill in the required fields to post. Your email address will not be published.